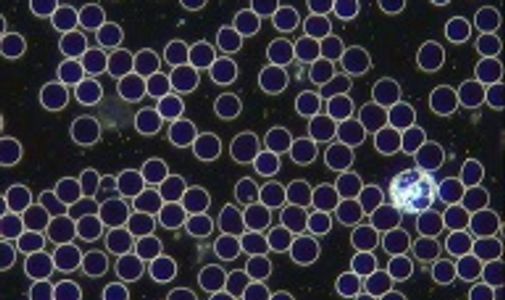

Somos Especialistas en Medicina Funcional y en el Tratamiento para la Menopausia
Somos Especialistas en Medicina Funcional y en el Tratamiento para la Menopausia
¡A través de una pantalla, vas a poder ver tu sangre en vivo!
Con el Hemaview, las doctoras expertas de Centro Engel determinarán tu nivel de estrés, el funcionamiento del Sistema Digestivo y la inflamación de tu intestino, el nivel de oxidación, la vitalidad de tus células y la presencia de bacterias, parásitos o cándida.
Asimismo, podrán diagnosticar algún problema hormonal, de coagulación o circulación, así como la oxigenación e hidratación celular, entre otros.

¡Todo esto en una sola gota de tu sangre!
Martes a viernes
De 9:00 a 18:00
Sábado
De 9:00 a 17:00
CDMX
Tel. 55 5280 0291
WhatsApp: 56 2485 2811
QUERÉTARO
Tel. 442 213 4789
WhatsApp: 442 817 5191
Citas y consultas en POLANCO, CDMX
Galileo 54, Polanco, Miguel Hidalgo,
C. P. 11560, Ciudad de México, México.
Citas y consultas en QUERÉTARO
Av. Manufactura 48, Local 5, Álamos 1a. Secc.,
C. P. 76160, Santiago de Querétaro, Qro.
Lic. Nut. Gysel R. Engel
Cédula profesional: 7557219
Universidad Iberoamericana
Usamos cookies para analizar el tráfico del sitio web y optimizar tu experiencia en el sitio. Al aceptar nuestro uso de cookies, tus datos se agruparán con los datos de todos los demás usuarios.